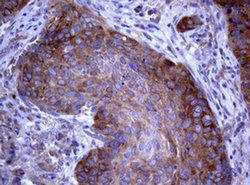
PIK3C2A Monoclonal Antibody (OTI3D9), TrueMAB , OriGene 100 &mu;L; Unconjugated:Antibodies,

Learn More
PIK3C2A Monoclonal Antibody (OTI3D9), TrueMAB™, OriGene
Mouse Monoclonal Antibody
Brand: Origene Technologies TA801694

Description
The protein encoded by this gene belongs to the phosphoinositide 3-kinase (PI3K) family. PI3-kinases play roles in signaling pathways involved in cell proliferation, oncogenic transformation, cell survival, cell migration, and intracellular protein trafficking. This protein contains a lipid kinase catalytic domain as well as a C-terminal C2 domain, a characteristic of class II PI3-kinases. C2 domains act as calcium-dependent phospholipid binding motifs that mediate translocation of proteins to membranes, and may also mediate protein-protein interactions. The PI3-kinase activity of this protein is not sensitive to omolar levels of the inhibitor wortmanin. This protein was shown to be able to be activated by insulin and may be involved in integrin-dependent signaling.Specifications
| PIK3C2A | |
| Monoclonal | |
| 1 mg/mL | |
| PBS with 1% BSA, 50% glycerol and 0.02% sodium azide | |
| O00443 | |
| PIK3C2A | |
| Human recombit protein fragment corresponding to amino acids 230-560 of human PIK3C2A produced in E.coli. | |
| 100 μL | |
| Primary | |
| Human | |
| Antibody | |
| IgG2a |
| Immunohistochemistry (Paraffin), Western Blot | |
| OTI3D9 | |
| Unconjugated | |
| PIK3C2A | |
| CPK, PI3-K-C2(ALPHA), PI3-K-C2A, PI3K-C2-alpha, PI3K-C2alpha | |
| Mouse | |
| Affinity Chromatography | |
| RUO | |
| 5286 | |
| -20° C, Avoid Freeze/Thaw Cycles | |
| Liquid |
The Fisher Scientific Encompass Program offers items which are not part of our distribution portfolio. These products typically do not have pictures or detailed descriptions. However, we are committed to improving your shopping experience. Please use the form below to provide feedback related to the content on this product.